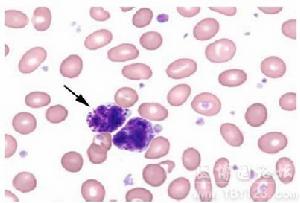
特發性嗜酸性粒細胞增多綜合症
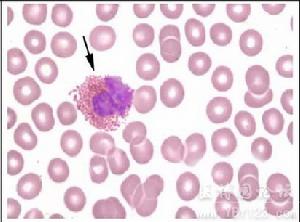
特發性嗜酸性粒細胞增多綜合症

簡介
 特發性嗜酸性粒細胞增多綜合症
特發性嗜酸性粒細胞增多綜合症病因
 特發性嗜酸性粒細胞增多綜合症
特發性嗜酸性粒細胞增多綜合症血液中嗜酸性粒細胞占白細胞總數的2%-4%,即100-350個細胞/μ1。血液中嗜酸性粒細胞的數目有明顯的晝夜周期性波動,清晨細胞數減少,午夜時細胞數增多。這種細胞數的周期性變化是與腎上腺皮質釋放糖皮質激素量的晝夜波動有關的。當血液中皮質激素濃度增高時,嗜酸性粒細胞數減少;而當皮質激素濃度降低時,細胞數增加。嗜酸性粒細胞的胞質內含有較大的、橢圓形的嗜酸性顆粒。這類白細胞也具有吞噬功能。嗜酸性粒細胞在體內的作用是:
①限制嗜鹼性粒細胞在速發性過敏反應中的作用。當嗜鹼性粒細胞被激活時,釋放出趨化因子,使嗜酸性粒細胞聚集到同一局部,並從三個方面限制嗜鹼性粒細胞的活性:一是嗜酸性粒細胞可產生前列腺素E使嗜鹼性粒細胞合成釋放生物活性物質的過程受到抑制;二是嗜酸性粒細胞可吞噬嗜鹼性粒細胞所排出的顆粒,使其中含有生物活性物質不能發揮作用;三是嗜酸性粒細胞能釋放組胺酶等酶類,破壞嗜鹼性粒細胞所釋放的組胺等活性物質。
 特發性嗜酸性粒細胞增多綜合症
特發性嗜酸性粒細胞增多綜合症②參與對蠕蟲的免疫反應。在對蠕蟲的免疫反應中,嗜酸性粒細胞有重要的作用。這類粒細胞的細胞膜上分布有免疫球蛋白Fc片斷和補體C3的受體。在已經對這種蠕蟲具有免疫性的動物體內,產生了特異性的免疫球蛋白IgE。蠕蟲經過特異性IgE和C3的調理作用後,嗜酸性粒細胞可藉助於細胞表現的Fc受體和C3受體粘著於蠕蟲上,並且利用細胞溶酶體內所含的過多氧化物酶等酶類損傷蠕蟲體。在有寄生蟲感染、過敏反應等情況時,常伴有嗜酸性粒細胞增多。
正常範圍:嗜鹼性粒細胞0~0.01(0~1%)。
症狀
臨床表現多樣,可有發熱、咳嗽、胸痛、心悸、氣短、神經精神症狀、瘙癢、皮疹、肝脾和淋巴結腫大、四肢末端水腫等。最嚴重的是心內膜下血栓形成和纖維化,腱索纖維化,導致房室瓣反流,最終發生進行性的充血性心力衰竭。超聲心動圖探查可用於診斷和監測。來自心臟的栓塞、瀰漫性腦病、周圍神經病,特別是多發性單神經炎是神經系統受累的主要表現。皮膚、呼吸系統和消化系統亦常受累,主要臟器累及者預後差。表現為血管性水腫者,心臟常不被累及,預後較好。
特發性嗜酸性粒細胞增多綜合症
特發性嗜酸性粒細胞增多綜合症2.腎外症狀 腎外器官受累症狀。
(1)心肺受累症狀:呼吸困難、充血性心力衰竭;咳嗽、胸痛、呼吸困難等。X 線檢查可見胸腔積液,約2/3 病例有瀰漫性間質浸潤。
(2)80%患者肝脾腫大,15%出現肝功能異常。
(3)1/3 患者有神經症狀,包括中樞性與外周性,如意識模糊、幻覺、精神失常、共濟失調、構音不清等。進一步發展為輕度偏癱或周圍神經炎。
(4)25%~50%的患者有皮膚病變,常見為斑丘疹和蕁麻疹。
3.腎臟受損害症狀 可出現腎病綜合徵表現,儘管發生率很低,但可能危及生命。Choi 等報告1 例18 歲男性患者,符合IHES 診斷標準,無其他免疫性疾病證據,出現腎病綜合徵和血尿。若明顯增高的嗜酸性粒細胞沒有造成器官的功能損害,患者可無症狀。1.一般症狀 常有發熱乏力盜汗貧血持續咳嗽胸痛皮膚瘙癢體重減輕氣急等症狀
2.嗜酸細胞浸潤各臟器的表現 可累及心肺中樞神經系統及造血系統出現回響的臨床症狀和體徵
二診斷標準
1.持續嗜酸細胞增高>1.5×109/L超過半年;
2.未發現引起嗜酸細胞增高的其他原因;
3.有多系統器官受累的證據
檢查
常用診斷
 特發性嗜酸性粒細胞增多綜合症
特發性嗜酸性粒細胞增多綜合症1.外周血嗜酸性粒細胞明顯增加(>1.5×109/L),並持續6 個月以上。
2.出現多系統臟器損害,無其他原因可以解釋。
3.不能找到可誘發嗜酸性粒細胞增多的常見病因。
符合上述3 項條件者,即可診斷為IHES。確診為IHES 的病人,出現腎損害的臨床表現和病理改變,並排除了其他免疫性疾病和全身性疾病,可診斷IHES並發腎損害。本病的參考診斷標準如下:外用血液中嗜酸性粒細胞的百分率超過正常值(7%)或絕對值超過正常數值(0.45×109/L)即可診斷為嗜酸性粒細胞增多症。根據嗜酸性粒細胞增多的程度,臨床上可分為輕、中、重三級。
(1)輕度:嗜酸性粒細胞絕對數小於1.5×109/L(1500/mm3),在白細胞分類中占15%以下。
(2)中度:嗜酸粒細胞絕對數為(1.5~5)×109/L(1500~5000mm3),分類中占15%~49%。
(3)重度:嗜酸粒細胞絕對數大於5×109/L(5000mm3),分類中占50%~90%。
實驗室檢查:
1.血象 外周血嗜酸性粒細胞增高,嗜酸性粒細胞的形態異常,白細胞分類中嗜酸性粒細胞>8%,嗜酸性粒細胞絕對值>0.4×109/L。外周血塗片中可見到不成熟的髓系細胞。可有輕度貧血、血小板數目異常。
2.骨髓象 骨髓增生活躍,粒系增生活躍,粒系早幼粒、中幼粒、晚幼粒、桿狀核、分葉核階段均可發現嗜酸性粒細胞。
3.寄生蟲病 糞便蟲卵檢查及寄生蟲皮膚過敏試驗陽性。
 特發性嗜酸性粒細胞增多綜合症
特發性嗜酸性粒細胞增多綜合症5.尿檢 腎臟受損害者可出現腎病綜合徵表現,尿檢可見蛋白尿和血。
其他輔助檢查:
由於目前積累病例數較少,尚未建立本病引起腎損害的病理特徵。不過已見有報導1 例IHES 並發腎病綜合徵患者。 (1).腎活檢 光鏡下可見嗜酸性粒細胞呈廣泛或結節性在腎組織內浸潤,並呈現典型免疫複合物型腎小球疾病的病理改變——毛細血管內增生。免疫螢光可見IgG 和C3 主要在內皮下沉積。電鏡下沉積物呈微管狀結構,直徑大小不等,20~80nm。(2).骨髓活檢 顯示細胞數正常或增多,可見輕度骨髓纖維化,巨核細胞數正常或減少;骨髓塗片上可偶見到Charcot Leyden 晶體,嗜酸性粒細胞平均占髓系細胞的30%。
治療
由於本病是嗜酸性細胞浸潤組織或嗜酸性細胞內含物的釋放所致,因而治療應試圖降低嗜酸性細胞計數.在進行性器官系統功能異常發生前是不必處理的,患者每隔3~6個月作一般性檢查一次.對器官系統的併發症應積極治療。
 特發性嗜酸性粒細胞增多綜合症
特發性嗜酸性粒細胞增多綜合症原發性高嗜酸性粒細胞綜合徵的治療不應周鏇於嗜酸性粒細胞的殺傷,應以治療原發病為主,可用腎上腺皮質激素治療,以減少嗜酸性粒細胞的浸潤。必要時加用羥基脲、長春新鹼或苯丁酸氮芥。對難治性或不能耐受上述治療者干擾素α 可能有效。 1.尋找病因進行治療。 2.對特發性高嗜酸性粒細胞增多綜合徵患者,可選用潑尼松1mg/(kg?d),1 次/d,可試用3 個月,如2~3 周內無效,可考慮予以羥基脲0.5g,2 次/d,使白細胞維持在(5~10)×109/L,逐步過渡到羥基脲0.5g,每周3~4 次,最後減至0.5g,每周2 次。如對上述兩藥無效時可考慮試用干擾素α 300 萬U,每天或隔天1 次,皮下注射。
預防
預防:主要措施是針對誘發病因加強預防和治療,以防止本病發生和進展。
預後:各種不同原因引起的嗜酸性粒細胞增多症,其預後相差懸殊,有必要鑑別出預後不良的伴有嗜酸粒細胞增多的疾病。IHES 患者未經治療,50%於1 年內死亡,平均存活為9 個月。20 世紀80 年代以來,使用激素、細胞毒類藥物等,5年生存率為20%~80%。
病例
 特發性嗜酸性粒細胞增多綜合症
特發性嗜酸性粒細胞增多綜合症近日我科收治一例男性患者,32歲,膽源性胰腺炎,結石性膽囊炎,膽總管結石,合併“特發性嗜酸性粒細胞增多綜合徵(I H E S )” 患者有“特發性嗜酸性粒細胞增多綜合徵(I H E S )” 病史8年口服“驍悉”等藥物治療。
1-查體:鞏膜黃染,上腹部壓痛陽性,肝臟未及腫大。2-腹部B超:胰腺體積增大,脾大。3-血常規 8.20 嗜酸 7.4% ,8.22 嗜酸 23% (未服藥)。4-血澱粉酶 654 。5-尿澱粉酶 1632 。6-肝功酶系均增高,TBIL148 , DBIL 96 ,腎功 電解質 正常。7-心電圖 提示:缺血改變。
目前給於抗感染、抑酸、抑酶、補液治療,患者現在手術指征明確,需手術治療。
1-患者有特發性嗜酸性粒細胞增多綜合徵(I H E S ),目前尚未發現明顯臟器功能不全。還需做那些評估、檢查? 2-此患者在多家三甲醫院就診均未選擇手術 。請問如果手術風險如何?IHES是否為手術禁忌? 3-如果選擇保守治療,有無靜脈藥物治療IHES(患者不能進食水)?治療胰腺炎與治療IHES的藥物有無矛盾?
收治過2例HES患者,以下僅供參考:
1、HES部分患者 FIP1L1-PDGFRA融合基因陽性,可以採用FISH或PCR檢測;
2、FIP1L1-PDGFRA融合基因陽性的HES患者,是格列衛治療的適應症;雖然推薦劑量是400mg,實際上很多病人100mg-200mg就能很好控制病情,但需要長期口服;
3、HES屬於嗜酸性細胞白血病範疇,但病程進展與一般意義上的急性白血病差別很多,慢很多,若患者一般情況可,並無嚴格手上禁忌,本病並非手術禁忌;此病人以前出現過心衰的表現,現在還在服用“地高辛,螺內酯”等藥物。因此我們對手術比較慎重。病人現在稍微飲水服藥就會出現劇烈腹痛,因此口服藥物也成了難題。
併發症
1.常見的併發症是心臟病變 心肌內膜下血栓形成和纖維化腱索纖維化導致房室瓣反流火罐網最終發生進行性充血性心力衰竭,超聲心動圖可用於診斷和監測勱。神經系統受累於來自心臟火罐網的栓子、瀰漫性腦病和周圍性神
特發性嗜酸性粒細胞增多綜合症
特發性嗜酸性粒細胞增多綜合症2.合併腎臟損害 嚴重者可出現氮質血症腎臟活檢勱發現多發性腎栓塞,腎間質嗜酸細胞浸潤等勱
3.浸潤性的心肌病;
4.瓣膜損害;
5.心力衰竭;
6.左心室二尖瓣血栓形成;
7.暫時性缺血性病變.
相似病症
 特發性嗜酸性粒細胞增多綜合症
特發性嗜酸性粒細胞增多綜合症引起周圍血嗜酸性粒細胞增多的原因很多如過敏寄生蟲感染化學藥物因素何杰金氏病包囊蟲病囊破裂等但各有其特殊表現參考一定實驗室檢查常可資確診
2.Crohn病:
本病可有噁心嘔吐腹痛腹瀉尤其當X線顯示黏膜有水腫腸壁增厚表現為回腸結腸炎者應與Crohn病進行鑑別周圍血嗜酸細胞增多則提示嗜酸性胃腸炎;腸道有瘺管狹窄的存在或腸炎性疾病的繼發表現(口炎關節炎等)則提示為Crohn1病
3.高嗜酸性粒細胞綜合徵:
高嗜酸性粒細胞綜合徵除外周血嗜酸性粒細胞增高外還伴有多系統多器官受累如心腦腎肺及皮膚也可累及胃腸道出現廣泛的胃腸道嗜酸性粒細胞浸潤本病病程短預後差因此如有明顯的胃腸道以外器官受累的臨床表現應考慮本綜合徵.

